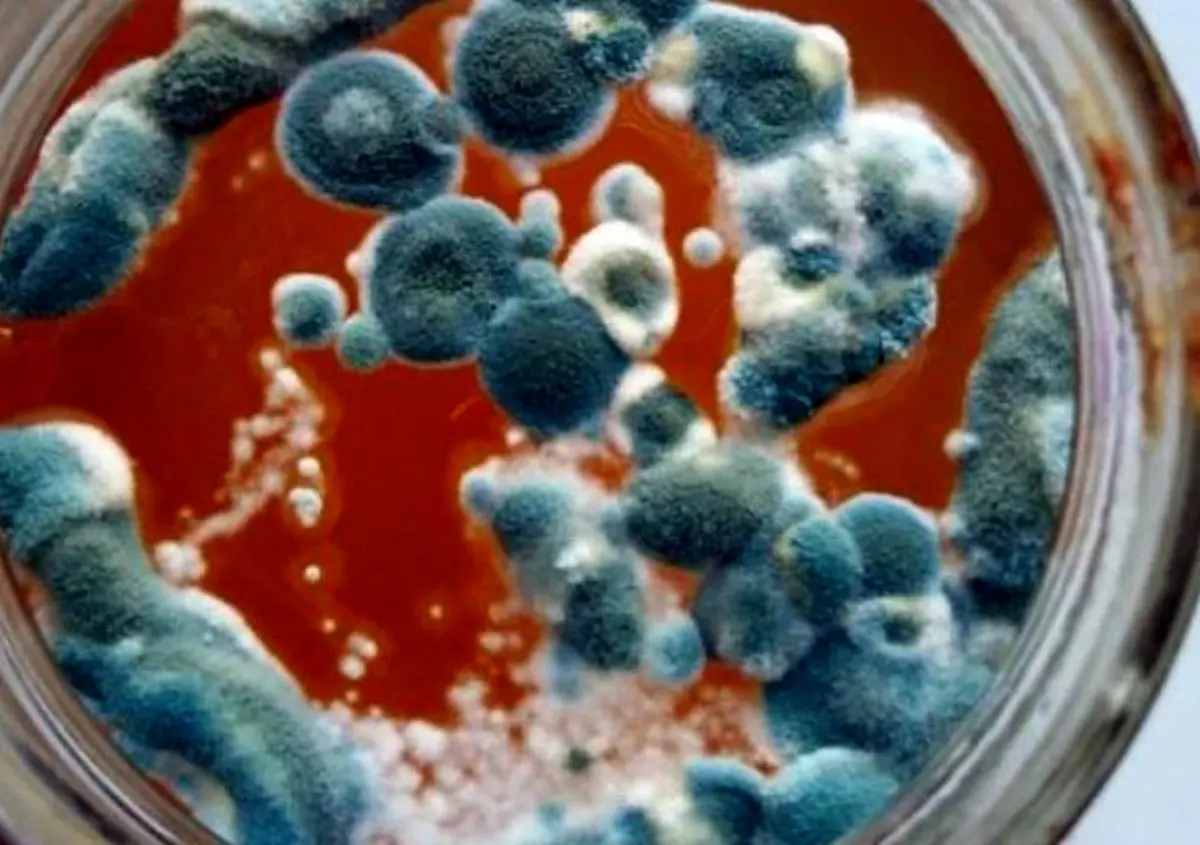
1

چرا رب کپک میزنه؟! چند تا راه ساده برای نجات رب کپک زده و راه های جلوگیری از آن

کپک زدن رب گوجه فرنگی یکی از مشکلات رایج است که با رعایت نکات ساده نگهداری می توان از آن جلوگیری کرد و رب را تازه نگه داشت.
شایانیوز- رب گوجه فرنگی یکی از چیزاییه که تو هر خونه ای پیدا میشه و هممون همیشه ازش استفاده موقع آشپزی استفاده میکنیم. وقتی میخوایم خورشت درست کنیم یا یه غذا رو خوش طعم کنیم، اولین کاری که می کنیم، رب رو اضافه می کنیم. ولی خیلی وقتا پیش میاد که وقتی میریم سراغ رب توی شیشه، می بینیم یه لایه کپک روش زده و خب دیگه نمیشه ازش استفاده کرد. این کپک هم اصلا خوشایند نیست و باعث میشه رب خراب بشه و ما هم ناراحت. حالا خیلی ها فکر میکنن کپک زدن رب یه چیز طبیعیه یا شاید به خاطر رب خراب باشه، اما واقعیتش اینه که کپک زدن دلایل مختلفی داره. مثلاً ممکنه به خاطر اینکه هوا وارد شده باشه، یا ظرفی که رب توش نگهداری میشه تمیز نباشه، یا اینکه رب تو جای گرم باشه. خلاصه کلی دلیل داره که باعث میشه کپک بزنه و رب خراب بشه. توی این مقاله میخوام به زبون ساده بگم چرا رب کپک میزنه و چطوری میشه جلوی این اتفاق رو گرفت. با چندتا نکته ساده و کوچیک می تونید ربتون رو سالم تر نگه دارید و دیرتر کپک بزنه. پس اگر دوست دارید ربتون همیشه تازه بمونه و از خراب شدنش جلوگیری کنید، این مقاله رو تا آخر بخونید که براتون کلی راهکار مفید دارم.

علل کپک زدن رب
کپک ها قارچ های میکروسکوپی هستند که در شرایط خاصی رشد می کنند و سطح رب را سفید، سبز، آبی یا سیاه رنگ می کنند. علل اصلی کپک زدن رب عبارتند از؛
وجود رطوبت و هوا: رب گوجه فرنگی به دلیل داشتن رطوبت و قرار گرفتن در معرض هوا، شرایط مناسبی برای رشد کپک فراهم می کند. ورود هوا باعث اکسید شدن رب و افزایش احتمال رشد قارچ ها می شود.
عدم رعایت بهداشت: استفاده از ظروف یا قاشق های آلوده هنگام مصرف یا برداشت رب، می تواند باکتری ها و کپک ها را به رب منتقل کند.
ذخیره سازی نامناسب: نگهداری رب در دمای بالا یا محیط های مرطوب، باعث افزایش رشد کپک می شود.
کمبود مواد نگهدارنده طبیعی: رب های خانگی که فاقد مواد نگهدارنده هستند، به دلیل نبود ترکیباتی مانند اسید سیتریک یا نمک کافی، بیشتر در معرض کپک زدن قرار دارند.
کیفیت پایین گوجه فرنگی اولیه: استفاده از گوجه های خراب یا نیمه فاسد، می تواند احتمال کپک زدن را افزایش دهد.

فرآیند کپک زدن
کپک ابتدا به صورت لکه های کوچک و سفید روی سطح رب ظاهر می شود. این لکه ها به مرور زمان بزرگ تر شده و به رنگ های سبز، سیاه یا آبی تغییر رنگ می دهند. کپک ها نه تنها باعث تغییر طعم و بو می شوند، بلکه می توانند سموم قارچی تولید کنند که مصرف آن ها خطرناک است.

روش های جلوگیری از کپک زدن رب
برای جلوگیری از کپک زدن رب گوجه فرنگی، می توان روش های مختلفی را به کار برد که مهم ترین آن ها عبارتند از؛
استفاده از ظروف مناسب: نگهداری رب در ظروف شیشه ای یا پلاستیکی با درب کاملا بسته، از ورود هوا و آلودگی جلوگیری می کند. بهتر است ظروف کاملاً تمیز و خشک باشند.
خنک نگه داشتن: نگهداری رب در یخچال یا محیط های خنک باعث کاهش سرعت رشد کپک می شود. دمای پایین، شرایط رشد قارچ ها را محدود می کند.
استفاده از قاشق تمیز: برای برداشت رب حتما از قاشق خشک و تمیز استفاده شود تا آلودگی وارد رب نشود.
افزودن مواد نگهدارنده طبیعی: ترکیباتی مانند نمک، سرکه یا اسید سیتریک می توانند به عنوان نگهدارنده طبیعی عمل کنند و رشد کپک را کاهش دهند.
تهیه رب با کیفیت: استفاده از گوجه های تازه و سالم برای تهیه رب، احتمال کپک زدن را کاهش می دهد.
پخت مناسب رب: پخت رب به مدت کافی باعث کاهش میزان رطوبت و از بین رفتن میکروارگانیسم ها می شود. رب های نیم پز یا خام بیشتر مستعد کپک زدن هستند.
روکش روغن: افزودن لایه نازکی از روغن بر روی سطح رب باعث جلوگیری از ورود هوا و رطوبت می شود که رشد کپک را مهار می کند.
بسته بندی صحیح: استفاده از بسته بندی های خلا یا بسته بندی با فناوری های نوین می تواند ماندگاری رب را افزایش داده و مانع کپک زدن شود.
در نهایت...
کپک زدن رب گوجه فرنگی مشکلی رایج اما قابل پیشگیری است که با رعایت نکات بهداشتی، نگهداری صحیح و استفاده از مواد نگهدارنده طبیعی می توان از آن جلوگیری کرد. اهمیت این مسئله در حفظ کیفیت و سلامت مصرف کننده بسیار بالا است و توجه به آن در تهیه و نگهداری رب ضروری می باشد. رعایت این نکات کمک می کند تا رب گوجه فرنگی سالم و با ماندگاری بالا در اختیار خانواده ها قرار گیرد.






















































































